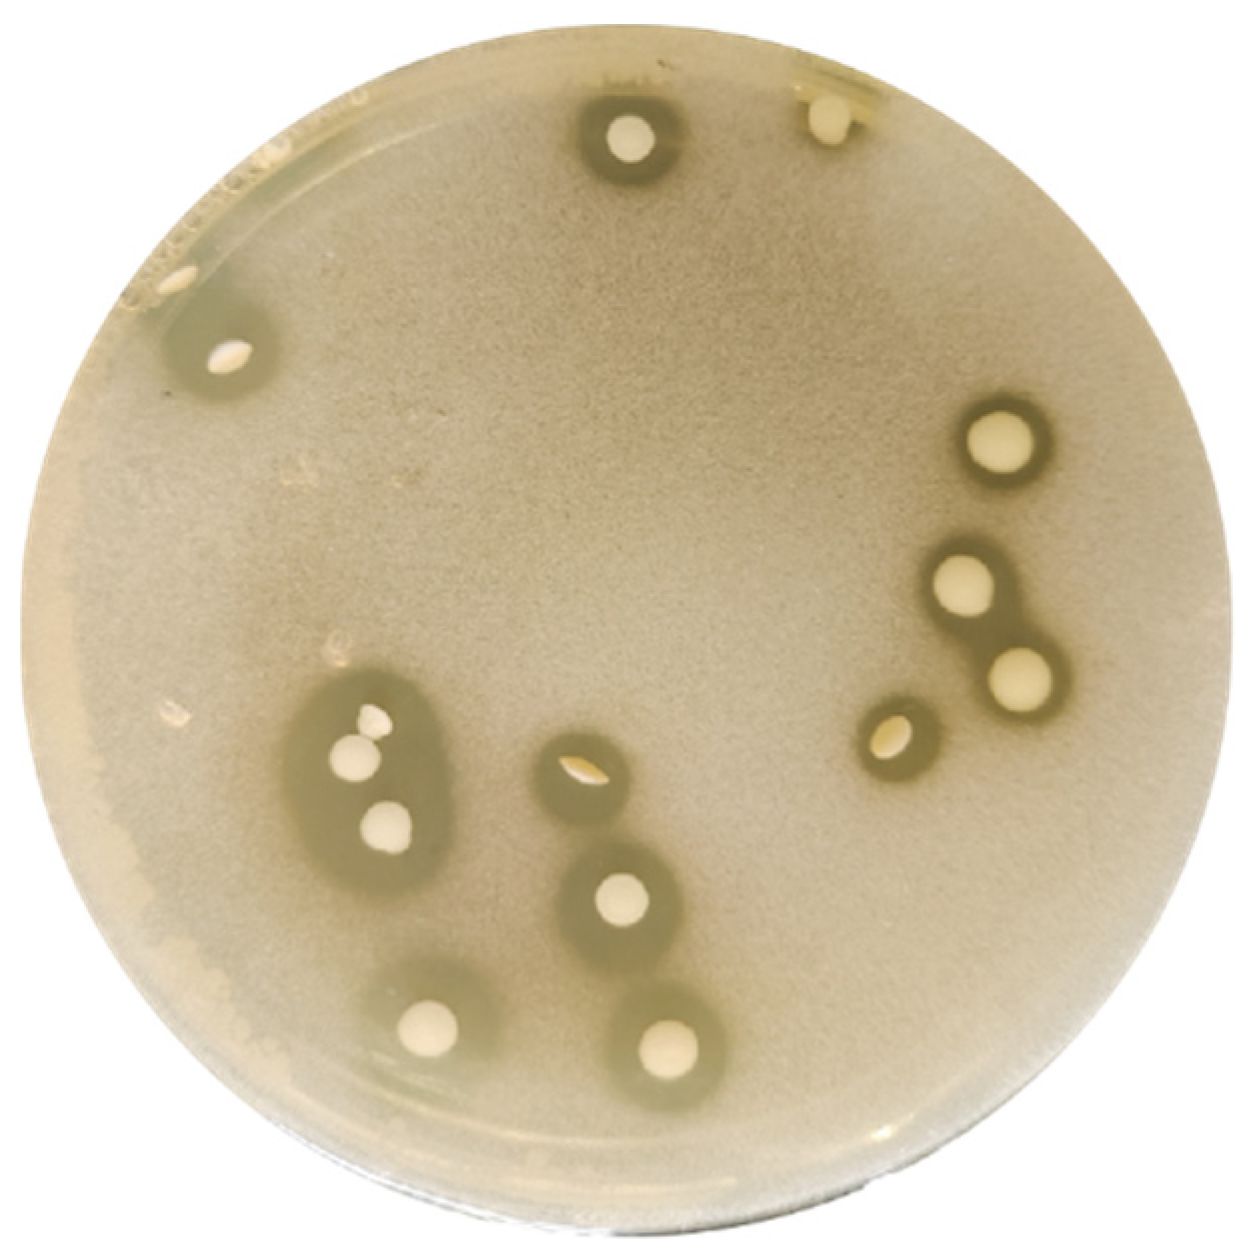
Foods 14 01851 g001

Lactiplantibacillus plantarum S1 as a Novel Dual-Functional Probiotic Strain for High-Efficiency Organoselenium Biotransformation in Functional Food Development
Abstract
1. Introduction
2. Materials and Methods
2.1. Reagents and Culture Media
2.2. Strain Isolation and Purification
2.3. Strain Identification
2.4. High-Density Cultivation of L. plantarum S1
2.5. Optimization of Se Enrichment Conditions for L. plantarum S1
2.6. Analysis of Se Speciation in Se-Enriched L. plantarum S1
2.7. Analytical Methods
2.7.1. Viable Cell Enumeration
2.7.2. Se Content Analysis
2.7.3. Biomacromolecule Quantification
2.7.4. Statistical Analysis
3. Results and Discussion
3.1. Strain Isolation and Taxonomic Identification
3.2. Optimization and Performance Evaluation of L. plantarum S1 High-Density Culture
3.3. Conversion of Inoranic to Organic Se by Se-Enriched L. plantarum S1
3.4. Se Specification in Se-Enriched L. plantarum S1
4. Conclusions
Supplementary Materials
Author Contributions
Funding
Institutional Review Board Statement
Informed Consent Statement
Data Availability Statement
Conflicts of Interest
References
- Monsen, E.R. Dietary reference intakes for the antioxidant nutrients: Vitamin C, vitamin E, selenium, and carotenoids. J. Am. Diet. Assoc. 2000, 100, 637–640. [Google Scholar] [CrossRef] [PubMed]
- Cizeikiene, D.; Juodeikiene, G.; Paskevicius, A.; Bartkiene, E. Antimicrobial activity of lactic acid bacteria against pathogenic and spoilage microorganism isolated from food and their control in wheat bread. Food Control 2013, 31, 539–545. [Google Scholar] [CrossRef]
- Jain, V.K.; Priyadarsini, K.I. Selenium compounds as promising antiviral agents. New J. Chem. 2024, 48, 6534–6552. [Google Scholar] [CrossRef]
- You, S.; Du, S.; Ge, G.; Wan, T.; Jia, Y. Selection of lactic acid bacteria from native grass silage and its effects as inoculant on silage fermentation. Agron. J. 2021, 113, 3169–3177. [Google Scholar] [CrossRef]
- Meng, T.-T.; Lin, X.; Xie, C.-Y.; He, J.-H.; Xiang, Y.-K.; Huang, Y.-Q.; Wu, X. Nanoselenium and selenium yeast have minimal differences on egg production and se deposition in laying hens. Biol. Trace Elem. Res. 2021, 199, 2295–2302. [Google Scholar] [CrossRef]
- Hadrup, N.; Ravn-Haren, G. Absorption, distribution, metabolism and excretion (ADME) of oral selenium from organic and inorganic sources: A review. J. Trace Elem. Med. Biol. 2021, 67, 126801. [Google Scholar] [CrossRef]
- Mamgain, R.; Mishra, G.; Kriti, S.; Singh, F.V. Organoselenium compounds beyond antioxidants. Future Med. Chem. 2024, 16, 2663–2685. [Google Scholar] [CrossRef]
- Pino, J.; Sauri-Duch, E.; Marbot, R. Changes in volatile compounds of Habanero chile pepper at two ripening stages. Food Chem. 2006, 94, 394–398. [Google Scholar] [CrossRef]
- Nie, X.Y.; Luo, D.Y.; Ma, H.F.; Wang, L.Y.; Yang, C.; Tian, X.K.; Nie, Y.L. Different effects of selenium speciation on selenium absorption, selenium transformation and cadmium antagonism in garlic. Food Chem. 2024, 443, 138460. [Google Scholar] [CrossRef]
- Thiry, C.; Schneider, Y.-J.; Pussemier, L.; De Temmerman, L.; Ruttens, A. Bioaccessibility and bioavailability in se-enriched food supplements. Biol. Trace Elem. Res. 2013, 152, 152–160. [Google Scholar] [CrossRef]
- Gao, L.; Li, X.L.; Li, Y.M.; Zhang, Z.K.; Wang, J.L.; Xu, C.; Wu, X. Biochemical characterization, biosynthesis mechanism, and functional evaluation of selenium-enriched Aspergillus oryzae A02. Int. J. Biol. Macromol. 2024, 275, 133714. [Google Scholar] [CrossRef] [PubMed]
- González-Salitre, L.; Román-Gutiérrez, A.; Contreras-López, E.; Bautista-Avila, M.; Rodríguez-Serrano, G.; González-Olivares, L. Promising use of selenized yeast to develop new enriched food: Human health implications. Food Rev. Int. 2023, 39, 1594–1611. [Google Scholar] [CrossRef]
- Nie, X.L.; Yang, X.R.; He, J.Y.; Liu, P.; Shi, H.; Wang, T.; Zhang, D.H. Bioconversion of inorganic selenium to less toxic selenium forms by microbes: A review. Front. Bioeng. Biotechnol. 2023, 11, 1167123. [Google Scholar] [CrossRef]
- Wu, J.; Hong, L.; Shi, M. Production of Methylselenocysteine in Saccharomyces cerevisiae LG6 by continuous fermentation. Bioresour. Technol. Rep. 2021, 13, 100627. [Google Scholar] [CrossRef]
- Ye, S.; Shen, F.; Jiao, L.; Xu, Z.; Wang, F. Biosynthesis of selenoproteins by Saccharomyces cerevisiae and characterization of its antioxidant activities. Int. J. Biol. Macromol. 2020, 164, 3438–3445. [Google Scholar] [CrossRef]
- Da Silva, T.F.; Glória, R.D.; Americo, M.F.; Freitas, A.D.; de Jesus, L.C.L.; Barroso, F.A.L.; Laguna, J.G.; Coelho-Rocha, N.D.; Tavares, L.M.; le Loir, Y.; et al. Unlocking the potential of probiotics: A comprehensive review on research, production, and regulation of probiotics. Probiotics Antimicrob. Proteins 2024, 16, 1687–1723. [Google Scholar] [CrossRef]
- Zaib, S.; Hayat, A.; Khan, I. Probiotics and their beneficial health effects. Mini-Rev. Med. Chem. 2024, 24, 110–125. [Google Scholar] [CrossRef]
- Pescuma, M.; Gomez-Gomez, B.; Perez-Corona, T.; Font, G.; Madrid, Y.; Mozzi, F. Food prospects of selenium enriched-Lactobacillus acidophilu CRL 636 and Lactobacillus reuteri CRL 1101. J. Funct. Foods 2017, 35, 466–473. [Google Scholar] [CrossRef]
- Yang, J.P.; Yang, H. Recent development in Se-enriched yeast, lactic acid bacteria and bifidobacteria. Crit. Rev. Food Sci. Nutr. 2023, 63, 411–425. [Google Scholar] [CrossRef]
- Zhang, Z.Q.; Niu, H.R.; Qu, Q.; Guo, D.M.; Wan, X.C.; Yang, Q.Q.; Mo, Z.H.; Tan, S.Y.; Xiang, Q.; Tian, X.; et al. Advancements in Lactiplantibacillus plantarum: Probiotic characteristics, gene editing technologies and applications. Crit. Rev. Food Sci. Nutr. 2025, 1–22, First online. [Google Scholar] [CrossRef]
- Abriouel, H.; Gómez, N.C.; Manetsberger, J.; Benomar, N. Dual effects of a bacteriocin-producing Lactiplantibacillus pentosus CF-6HA, isolated from fermented alorena table olives, as potential probiotic and antimicrobial agent. Heliyon 2024, 10, e28408. [Google Scholar] [CrossRef] [PubMed]
- Wang, Y.P.; Ma, H.Y.; Li, H.L.; Huang, Y.H.; Tang, Y.P.; Tang, X.X.; Sun, P.T.; Tan, Z.F.; Pang, H.L.; Yang, F.Y. Selenium-Enriched Lactiplantibacillus plantarum ZZU 8-12 Regulates Intestinal Microbiota and Inhibits Acute Liver Injury. Probiotics Antimicrob. Proteins 2025, 1–13, First online. [Google Scholar] [CrossRef]
- Che, X.H.; Shang, X.C.; Xu, W.; Xing, M.Q.; Wei, H.J.; Li, W.; Li, Z.W.; Teng, X.H.; Geng, L.W. Selenium-enriched Lactiplantibacillus plantarum alleviates alkalinity stress-induced selective hepatic insulin resistance in common carp. Int. J. Biol. Macromol. 2025, 305, 141204. [Google Scholar] [CrossRef]
- Song, Y.Y.; Zhang, J.; Li, Y.D.; Wang, Y.X.; Wan, Y.X. Potential Protective Effect of Selenium-Enriched Lactobacillus plantarum on Cadmium-Induced Liver Injury in Mice. J. Microbiol. Biotechnol. 2024, 34, 1328–1339. [Google Scholar] [CrossRef]
- Yazdi, M.; Mahdavi, M.; Kheradmand, E.; Shahverdi, A.J.A. The preventive oral supplementation of a selenium nanoparticle-enriched probiotic increases the immune response and lifespan of 4T1 breast cancer bearing mice. Arzneimittelforschung 2012, 62, 525–531. [Google Scholar] [CrossRef]
- Li, Y.L.; Wang, T.; Liu, D.Q.; Zhang, C.C.; Wu, W.C.; Yi, H.X.; Zhang, J.M. Biotransformation of inorganic selenium into selenium nanoparticles and organic selenium by Lactiplantibacillus plantarum CXG4. Food Biosci. 2025, 65, 106060. [Google Scholar] [CrossRef]
- Wang, B.Y.; Zhao, N.; Li, J.; Xu, R.Y.; Wang, T.R.; Guo, L.; Ma, M.; Fan, M.T.; Wei, X.Y. Selenium-enriched Lactobacillus plantarum improves the antioxidant activity and flavor properties of fermented Pleurotus eryngii. Food Chem. 2021, 345, 128770. [Google Scholar] [CrossRef]
- Peñas, E.; Martinez-Villaluenga, C.; Frias, J.; Sánchez-Martínez, M.J.; Pérez-Corona, M.T.; Madrid, Y.; Cámara, C.; Vidal-Valverde, C. Se improves indole glucosinolate hydrolysis products content, Se-methylselenocysteine content, antioxidant capacity and potential anti-inflammatory properties of sauerkraut. Food Chem. 2012, 132, 907–914. [Google Scholar] [CrossRef]
- Wang, H.J.; Yang, S.L.; Chen, Y.; Wang, Z.L.; Yuan, Y.H.; Yue, T.L. Comprehensive distribution and species of selenium in Se-enriched Pichia kudriavzevii 1845. Food Chem. 2024, 438, 137966. [Google Scholar] [CrossRef] [PubMed]
- Dong, X. Manual of Systematic Identification of Common Bacteria; Science Press: Beijing, China, 2001. [Google Scholar]
- Ling, D. Classification, Identification, and Experimental Methods of Lactic Acid Bacteria; China Light Industry Press: Beijing, China, 1999. [Google Scholar]
- Zhao, L.; Zhao, G.; Zhao, Z.; Chen, P.; Tong, J.; Hu, X. Selenium distribution in a Se-enriched mushroom species of the genus Ganoderma. J. Agric. Food Chem. 2004, 52, 3954–3959. [Google Scholar] [CrossRef]
- Pieniz, S.; Andreazza, R.; Mann, M.B.; Camargo, F.; Brandelli, A. Bioaccumulation and distribution of selenium in Enterococcus durans. J. Trace Elem. Med. Biol. 2017, 40, 37–45. [Google Scholar] [CrossRef] [PubMed]
- Chen, Y.; Zeng, W.; Liu, Y.; Zhao, D.; Lei, H.; Zhang, Y.; Jia, X. Optimization of extraction process of selenium enriched protein from Enterobacterium and study on its antitumor and antioxidant effects in vitro. Food Sci. Technol. 2023, 48, 201–209. [Google Scholar]
- Staub, A.M.; Whistler, R.L. (Eds.) Removal of Proteins: Sevag Method. Methods in Carbohydrate Chemistry; Academic Press, Inc.: New York, NY, USA, 1965; pp. 5–6. [Google Scholar]
- Wang, X.-F.; Chen, Y.-Y.; Tao, G.-Q. Extraction and determination of nucleic acid of selenium-yeast. Food Sci. Technol. 2006, 78–80. [Google Scholar] [CrossRef]
- Institute of Nutrition and Food Safety. National Food Safety Standard—Microbiological Examination of Food—Lactic Acid Bacteria Examination; National Health and Family Planning Commission of the People’s Republic of China, State Food and Drug Administration: Beijing, China, 2016; pp. 1–10. [Google Scholar]
- Gawloska-Kamocka, A. The determination of content of selenium in natural fruit juices by spectral methods. Rocz. Panstw. Zakl. Hig. 2008, 59, 173–178. [Google Scholar]
- Bradford, M.M. A rapid and sensitive method for the quantitation of microgram quantities of protein utilizing the principle of protein-dye binding. Anal. Biochem. 1976, 72, 248–254. [Google Scholar] [CrossRef]
- Albalasmeh, A.A.; Berhe, A.A.; Ghezzehei, T.A. A new method for rapid determination of carbohydrate and total carbon concentrations using UV spectrophotometry. Carbohydr. Polym. 2013, 97, 253–261. [Google Scholar] [CrossRef]
- Efiok, B.; Eduok, E. Basic Calculations for Chemical and Biological Analysis, 2nd ed.; AOAC International: Rockville, MD, USA, 2000. [Google Scholar]
- Orgeron, R.; Corbin, A.; Scott, B. Sauerkraut: A Probiotic Superfood. Funct. Foods Health Dis. 2016, 6, 536–543. [Google Scholar] [CrossRef]
- Zhou, H.; Wang, S.; Liu, W.; Chang, L.; Zhu, X.; Mu, G.; Qian, F. Probiotic properties of Lactobacillus paraplantarum LS-5 and its effect on antioxidant activity of fermented sauerkraut. Food Biosci. 2023, 52, 102489. [Google Scholar] [CrossRef]
- Rattu, G.; Krishna, P.M. Enzyme-free colorimetric nanosensor for the rapid detection of lactic acid in food quality analysis. J. Agric. Food Res. 2022, 7, 100268. [Google Scholar] [CrossRef]
- Cui, S.M.; Zhao, J.X.; Zhang, H.; Chen, W. High-density culture of Lactobacillus plantarum coupled with a lactic acid removal system with anion-exchange resins. Biochem. Eng. J. 2016, 115, 80–84. [Google Scholar] [CrossRef]
- Krzywonos, M.; Eberhard, T. High density process to cultivate Lactobacillus plantarum biomass using wheat stillage and sugar beet molasses. Electron. J. Biotechnol. 2011, 14, 6. [Google Scholar] [CrossRef]
- Pan, D.D.; Liu, J.; Zeng, X.Q.; Liu, L.; Li, H.; Guo, Y.X. Immunomodulatory activity of selenium exopolysaccharide produced by Lactococcus lactis subsp. Lactis. Food Agric. Immunol. 2015, 26, 248–259. [Google Scholar] [CrossRef]
- Jin, W.; Yoon, C.; Johnston, T.V.; Ku, S.; Ji, G.E. Production of selenomethionine-enriched Bifidobacterium bifidum BGN4 via sodium selenite biocatalysis. Molecules 2018, 23, 2860. [Google Scholar] [CrossRef]
- Suhajda, A.; Hegoczki, J.; Janzso, B.; Pais, I.; Vereczkey, G. Preparation of selenium yeasts I. Preparation of selenium-enriched Saccharomyces cerevisiae. J. Trace Elem. Med. Biol. 2000, 14, 43–47. [Google Scholar] [CrossRef]
- Kieliszek, M.; Błażejak, S.; Gientka, I.; Bzducha-Wróbel, A. Accumulation and metabolism of selenium by yeast cells. Appl. Microbiol. Biotechnol. 2015, 99, 5373–5382. [Google Scholar] [CrossRef]

: Yield of organic Se;
: viable bacterial count.
: Yield of organic Se;
: viable bacterial count.

Disclaimer/Publisher’s Note: The statements, opinions and data contained in all publications are solely those of the individual author(s) and contributor(s) and not of MDPI and/or the editor(s). MDPI and/or the editor(s) disclaim responsibility for any injury to people or property resulting from any ideas, methods, instructions or products referred to in the content. |
© 2025 by the authors. Licensee MDPI, Basel, Switzerland. This article is an open access article distributed under the terms and conditions of the Creative Commons Attribution (CC BY) license (https://creativecommons.org/licenses/by/4.0/).
Share and Cite
Yuan, L.; Yuan, J.; Gao, C.; Zhao, H.; Wu, C.; Yang, Z.-H. Lactiplantibacillus plantarum S1 as a Novel Dual-Functional Probiotic Strain for High-Efficiency Organoselenium Biotransformation in Functional Food Development. Foods 2025, 14, 1851. https://doi.org/10.3390/foods14111851
Yuan L, Yuan J, Gao C, Zhao H, Wu C, Yang Z-H. Lactiplantibacillus plantarum S1 as a Novel Dual-Functional Probiotic Strain for High-Efficiency Organoselenium Biotransformation in Functional Food Development. Foods. 2025; 14(11):1851. https://doi.org/10.3390/foods14111851
Chicago/Turabian StyleYuan, Lin, Jianfeng Yuan, Chen Gao, Haoming Zhao, Chengye Wu, and Zhong-Hua Yang. 2025. "Lactiplantibacillus plantarum S1 as a Novel Dual-Functional Probiotic Strain for High-Efficiency Organoselenium Biotransformation in Functional Food Development" Foods 14, no. 11: 1851. https://doi.org/10.3390/foods14111851
APA StyleYuan, L., Yuan, J., Gao, C., Zhao, H., Wu, C., & Yang, Z.-H. (2025). Lactiplantibacillus plantarum S1 as a Novel Dual-Functional Probiotic Strain for High-Efficiency Organoselenium Biotransformation in Functional Food Development. Foods, 14(11), 1851. https://doi.org/10.3390/foods14111851

